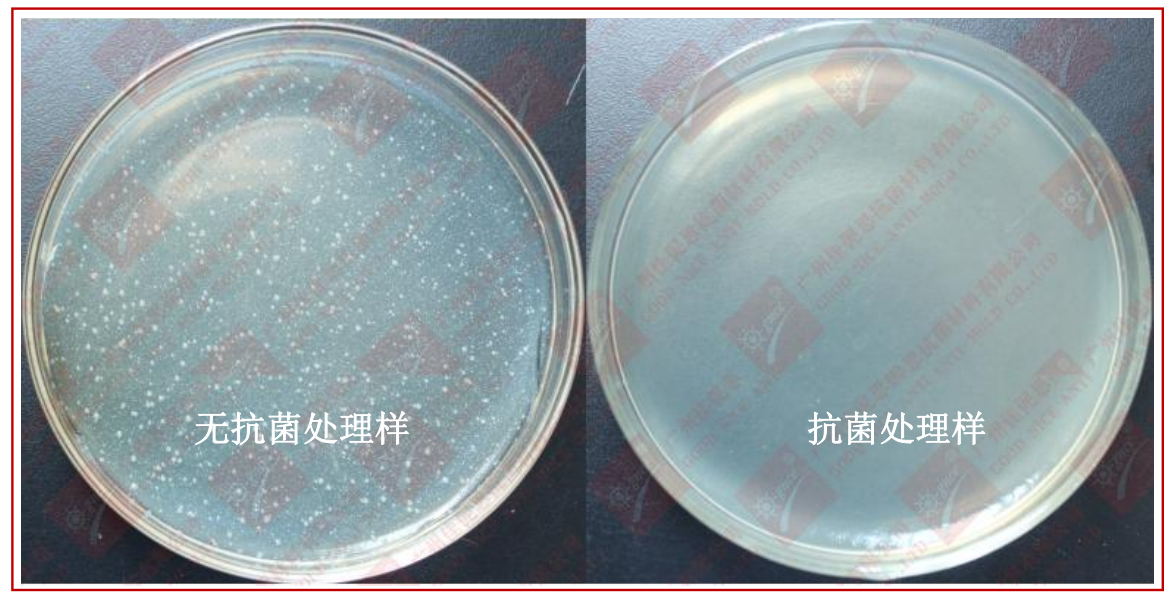
1677049006056.png image.png

概述
防霉抗菌剂 AEM570-F3 主要用于光滑表面的防霉抗菌,形成一层抗菌膜,可牢固的结合在金属表面,可以防止微生物所引起的危害,使处理后的表面具有抗菌作用。
1.广谱抗菌性:具有非常广泛的抗菌效果,对上多种细菌都具明显抗菌效果;
2.抗菌效率高:对金黄色葡萄球菌、绿脓杆菌、大肠杆菌等多种病菌的抗菌率可达 99%;
3.防霉性能:对黑曲霉、黄曲霉、杂色曲霉、绳状青霉、球毛壳霉、短柄帚霉、土曲霉等多种霉菌具有抑杀效果;
4.效果持久:不流失、不水解,缓释剂的作用减缓抗菌成分的释放,具有持久抗菌效果;
5.热稳定性好,耐高温,分解温度大于 200℃;
6.环保低毒:AEM5700-F3 符合相关环保要求,经过相关 Reach、Rohs、不含 DMF 等相关环保检测认证。
适用范围
◎适用于不锈钢、铝、铜、铁、锡等金属材料表面的抗菌。
◎适用于非金属材料表面的抗菌。
使用方法
1.整个操作过程中请戴手套和口罩,勿直接接触此防霉抗菌剂。
2.操作间配备抽风装置,具有良好的通风条件、并且干净、少灰尘。
3.使用前先将须处理的产品表面灰尘等清洁干净。
4.用喷枪喷洒,具体操作如下。
①将防霉抗菌剂倒入喷枪,调节喷枪出液量至较低,使单次喷出量不宜过多;
②喷枪与被喷物间的距离建议在 15-20cm;
③用量:确保喷在物品表面有薄薄的一层即可,用量大概 4-6g/㎡;
④自然干燥成膜或 60-80℃烘干成膜,具体烘干温度、时间需具体实验调整。
5.喷枪不用时,需用溶剂如丁酯或酒精等洗枪,以免堵塞。
6.防霉抗菌剂未用完的及时倒回原桶,密封保存,否则会固化结块,导致无法使用。
温馨提示
1.使用时请勿用手直接接触,尤其是不能接触到眼睛或鼻子,操作过程中请佩戴口罩和橡胶手套。
2.若抗菌剂不慎接触皮肤,请及时用肥皂水彻底清洗。
3.喷枪不用时,若有防霉抗菌剂,可倒出,用溶剂清洗喷枪,以免堵塞。
使用效果
-
金属抗菌剂
点击收藏 查看详情 -
银离子抗菌剂
点击收藏 查看详情 -
ABS抗菌母粒
点击收藏 查看详情 -
银离子洗衣液抗菌剂点击收藏 查看详情
-
锌类抗菌剂点击收藏 查看详情
-
固体硅胶抗菌膏点击收藏 查看详情






